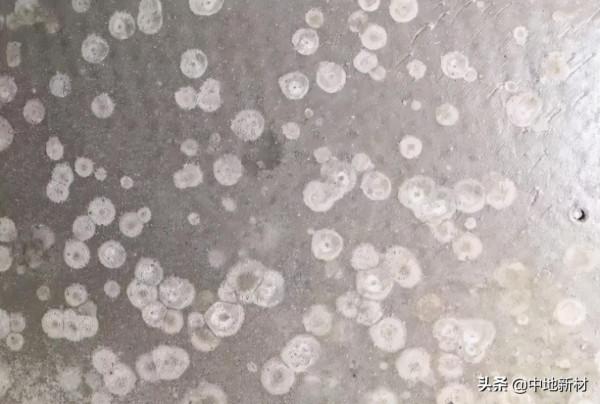
自流平驗收工程，如何做到明察秋毫？

年關將至,許多家居裝修工程都在趕工,有些甚至已陸續接近了尾聲,工程專案驗收也越來越多。隨著趕工期和驗收期的到來,許多施工過程中出現的問題,也會越來越多,很多人在工程驗收時,總想不起要注意哪些方面,今天“中地小課堂”就給大家來個年終小總結,總結在地面找平施工中,最常遇到的問題和驗收時要注意的事項。
讓大家無論在施工中,或工程驗收時都能做到“明察秋毫”!
自流平施工中常見問題
起粉
自流平施工對加水量有嚴格要求,但實際上,有些運用水泥基自流平施工中,往往為了高流動性加入過量的水進行攪拌,當施工到基面上時,水分會慢慢積聚到找平層表面,提高了找平層表面的水灰比,導致表面強度快速下降。在高溫或乾燥氣候下,水分蒸發快,實際造成的影響較小,但是當溫度較低或者環境溼度大,水分不易蒸發時,往往會造成表面起粉的現象。
當出現表面起粉的現象時,應剷除表面的粉塵,並清理乾淨,用滲透性強介面處理劑進行加強處理,比如說中地新材的固砂寶(→關於固砂寶的可以點這裡)表面強度可得到一定提升。
大面積起泡
氣泡出現的原因很多,基本上都是不懂自流平的施工工藝,一些步驟操作不當導致的:
1、自流平水泥兌水兌多了。
2、攪拌的時間不夠,材料沒有攪拌均勻。
3、攪拌後沒有靜置半小時。
4、在鋪自流平水泥時,沒有用帶齒的滾筒滾動過,沒有排出氣泡。
5、介面劑沒有乾透就鋪自流平。
這種情況可以先試試拿砂紙或者打磨機對著有氣泡的地方打磨一遍,打磨之後再做吸塵處理。
其實最好的方法,我們還是建議用中地新材瓷性找平寶,注意好幾點事項,完全可以避免出現大面積的起泡:
1、攪拌好的自流平儘量在半個小時之內使用。
2、把自流平水泥倒在地面上,用帶齒的靶子把自流平靶開,根據要求的厚度靶到不同大小的面積。
3、待自流平自然流平後用帶齒的滾子在上面縱橫滾動,放出其中的氣體,防止起泡。
4、自流平乾透前不可進行下一步的施工。
5、自流平大面積施工中,施工厚度特別薄,穿戴普通鞋子會整體粘帶起來,無法進行,所以必須自流平釘鞋。
流動性差、沉澱較快
流動性差,一般出現在自流平材料的質量,材料水灰比的配比不對,加水超量,材料沉降,導致自流平在施工中出現沉澱過快的現象。待自流平幹了以後很容易出現分層的現象,區域性基層低窪部分會出現起皺現象。也不會像有些工人想象的,材料越稀反而會出現沉澱過快的問題。只有按照規定的水灰比充分攪拌,最好是二次攪拌,這樣才能做出更好的效果。
中地新材瓷性找平寶自流平就不會出現這樣的問題,材料本身的優勢就是不沉降,體積穩定,通體強度一致,流動性優(詳細可以點這裡《技術貼|自流平流動性強到底有多重要》)。而且流動速度快,更能提高施工效率。
施工驗收注意事項:
地面找平要哪些驗收標準?(最好請專業人員進行驗收。地面找平驗收需要看地面平整度、地面顏色等)。
地面找平後,地面的顏色要均勻無異樣,此外表層應該沒有裂縫、起砂等問題出現。與牆面驗收一樣,也需要檢查地面是否存在空鼓、粘結不牢等問題。
地面找平完工後,一般都是用一根兩米的靠尺來進行地毯式測量。即在同一位置至少進行交叉方向的測量、如果在靠尺的下方出現了大於3毫米甚至是5毫米的空隙。這就說明地面不平,已經超出地板的鋪裝要求了。
除此之外,如果想驗收時沒有問題,還要注意地面找平的施工環境。好的施工環境才能事半功倍,如果當時的天氣或是溫度等不適合施工,需要等到適宜的環境下再施工。
其次需要注意地面的水電路管道,一般因為業主的需求會對水電進行改造,找平時在遇到
檢查得越細緻,自流平找平質量才會越高,當然如果運用的是瓷性找平寶自流平,施工當中嚴格按要求作業,相信以上的常見問題就不會出現。把好施工中的每一關,才能讓你的家住著更安心。
今天的小課堂就到這裡,
還想了解哪些自流平施工中的問題,
歡迎在後臺留言,我們一起探討!